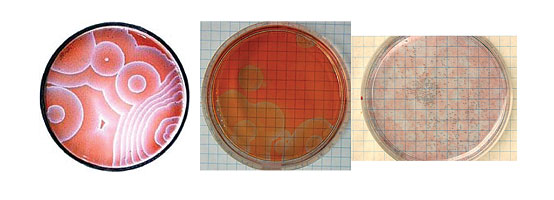

news hofstra university new york hofstra university

ev dissipative structure のアイデア 20 件 カオス理論 位相幾何学 熱力学

phase diagrams for the belousov zhabotinsky reaction a isospike download scientific diagram

非線形科学 集英社新書 蔵本由紀 科学 テクノロジー kindleストア amazon

amazon boundless style a mix and match sewing pattern workbook boos kristiann sewing

日本ヴォーグ社の基礎book 刺しゅう

reconfigurable assemblies of active autochemotactic gels pnas

kimura don tokyo mr design tokyo logo design poster

researchgate

アマゾン

msurj 2019 2020 by mcgill science undergraduate research journal issuu

アマゾン

picturing science and engineering felice frankel
news hofstra university new york hofstra university

amazon boundless style a mix and match sewing pattern workbook boos kristiann sewing

pinterest

amazon elements of the history of mathematics bourbaki nicolas history of mathematics

ev dissipative structure のアイデア 20 件 カオス理論 位相幾何学 熱力学

predicting complex biology with simple chemistry pnas

energy the urban technologist

amazon morphogenesis and pattern formation in biological systems experiments and models sekimura t noji s ueno n maini philip communicable diseases

https www mdpi com 2073 445x 10 3 296 htm

the rspec book professional ruby series

watts up with that

libro de ponencias cdc harvard 2008 by rodrigo martin issuu

増補新装版 ベクシンスキー パン エキゾチカ ズジスワフ ベクシンスキー 本 通販 amazon

小倉ゆき子のビーズ刺しゅうの基礎 小倉ゆき子 本 通販 amazon

ベロウソフ ジャボチンスキー反応 belousov zhabotinsky bz reaction chem station ケムステ

elte chemical kinetics lab
You May Like